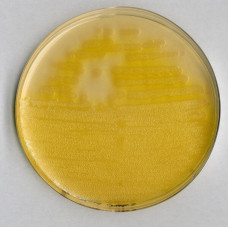
AGAR F PARA PSEUDOMONAS 500GR MERCK

AMOSTRADOR C/MEIO P/BACTERIAS TOTAIS VAL. MINIMA: 3 MESES, CX C/ 25 UND MILLIPORE
Modelo: MSSK10025
R$4.236,57


AGAR TEAGUE (EOSIN METHYLENE BLUE LACTOSE SUCROSE AGAR) MERCK - EMB 500G
Modelo: 1038580500
R$1.129,21

AGAR SELETIVO PARA LISTERIA OXFORD (BASE) P/ MICROBIOLOGIA MERCK (EMB. 500GR)
Modelo: 1070040500